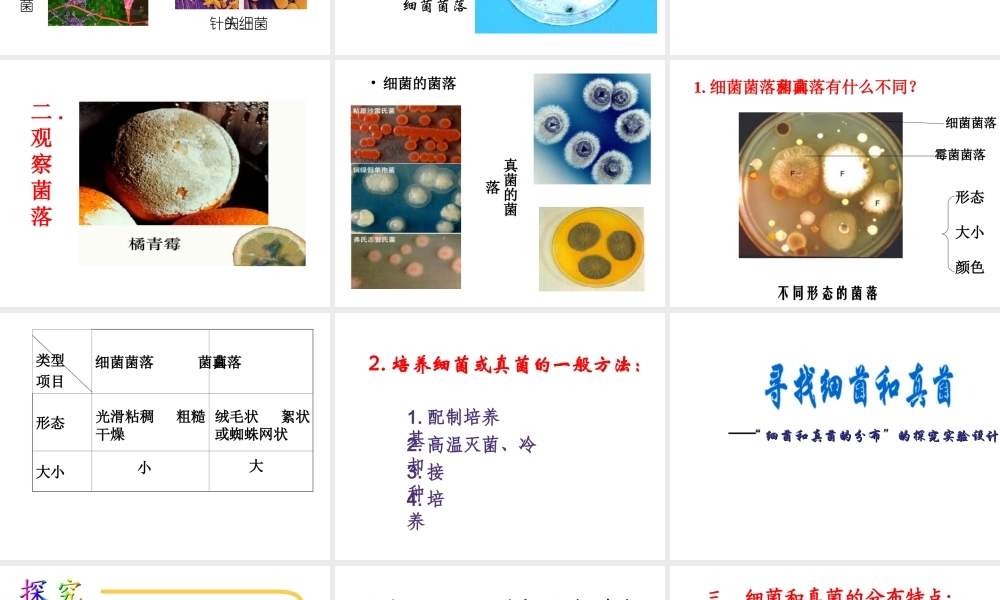
八年级生物上册 第五单元第五章细菌和真菌在生物圈中的作用课件 人教新课标版

当你在大自然中畅游的时候,印入眼帘的生物大多数是动物和植物,偶尔还能见到蘑菇,可是还有许多的生物你用肉眼是看不见的
老师将带你去寻找……分布广泛的细菌和真菌发霉桔子生活中的细菌 抹布和砧板上的细菌 针头上的细菌霉菌菌落细菌菌落菌落一
菌落 一个细菌或真菌繁殖后形成的肉眼可见的集合体二
观察菌落• 细菌的菌落 真菌的菌落不同形态的菌落 细菌菌落霉菌菌落形态大小颜色1
细菌菌落和真菌菌落有什么不同
类型项目细菌菌落真菌菌落形态大小光滑粘稠 粗糙干燥绒毛状 絮状或蜘蛛网状小大2
培养细菌或真菌的一般方法:1
配制培养基2
高温灭菌、冷却3
培养““ 细菌和真菌的分布”的探究实验设计细菌和真菌的分布”的探究实验设计探究:检测不同环境中的细菌和真菌提出问题:______________做出假设:______________实验方案:______________探究:检验不同环境中的细菌和真菌问题:不同环境中都有细菌和真菌吗
哪种环境中更多一些
哪种环境中少一些
哪种环境中根本没有
细菌和真菌的分布特点:• 在生物圈中广泛分布土壤水体空气工农业产品人体及动物极端环境极端环境生存基本条件1
适宜的温度3
有的还需要特殊条件四
细菌和真菌的生活需哪些基本条件
科学家在深海的火山口等极端特殊的环境中,发现了古细菌
古细菌的存在说明了什么问题
练习炎热的夏季,事物容易腐败,得肠胃炎的人也较多,这是为什么
洗干净的衣服不会长霉,而脏衣服就容易长霉,这是为什么
某同学在琼脂培养基上接种了两种细菌 A 、 B 进行培养,同时在培养基上放上了盐水浸过的滤纸片
经过恒温培养一天后,盐纸片周围只有 A 细菌生长
你对这个实验结果怎样解释
你见过泡菜坛吗
制作泡菜的原理就是利用乳酸菌使蔬菜中的有机物生成乳酸
泡菜坛的结构,既要加盖,还